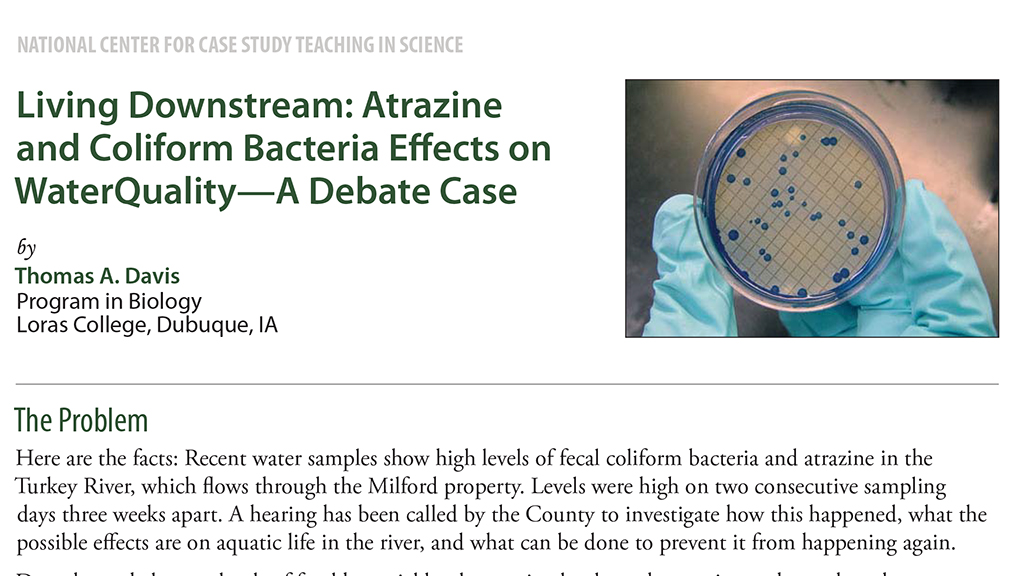

Abstract
In this case, developed for a course in Issues in Environmental Biology, students learn that water samples collected from a local river show elevated levels of fecal bacteria and atrazine, one of the most commonly used herbicides in the United States. A hearing has been called by the county to investigate the cause of the contamination, possible effects on aquatic life in the river, and what can be done to prevent a recurrence. In the ensuing debate, students must analyze and interpret data as they present the viewpoints of various stakeholders, ranging from the landowners' right to apply atrazine to control weeds, to the responsibility of fisheries biologists and water quality specialists to protect the environment.